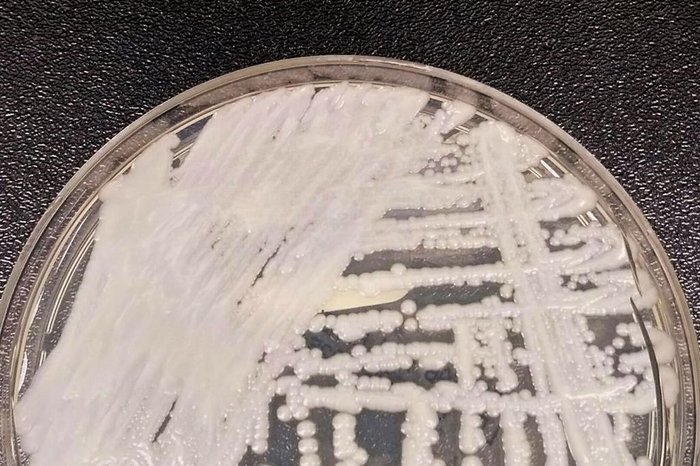
Centers For Disease Control and Prevention / Divulgação

A Secretaria Estadual de Saúde de Minas Gerais confirmou quatro casos do “superfungo” Candida auris, até esta quarta-feira (16), no Hospital João XXIII, em Belo Horizonte. Outros 24 estão em análise.
A identificação acende um alerta entre órgãos e profissionais de saúde em função de sua resistência aos tratamentos disponíveis e capacidade de adaptação. A espécie não costuma oferecer riscos a pessoas saudáveis, mas pode causar infecções com alto nível de mortalidade naquelas que já estão com o sistema imunológico debilitado.
O Candida auris foi identificado pela primeira vez em 2009, no Japão. No Brasil, o primeiro caso ocorreu em um hospital de Salvador, na Bahia, em dezembro de 2020.
De acordo com a Fundação Oswaldo Cruz (Fiocruz), o maior surto já registrado em território brasileiro foi entre novembro de 2021 e fevereiro de 2022, no município de Recife, em Pernambuco, com 48 casos. Em 2023, três novas ocorrências foram identificadas no município.
Uma nota técnica da Agência Nacional de Vigilância Sanitária (Anvisa), publicada em 2022, apresenta o Candida auris como “um fungo emergente que representa uma grave ameaça à saúde global, pois pode causar infecções invasivas, que são associadas à alta mortalidade, pode ser multirresistente e levar à ocorrência de surtos em serviços de saúde”. O documento apresenta orientações para identificação, prevenção e controle de infecções pelo fungo nas instituições e se mantém válido, conforme a assessoria de imprensa do órgão.
No Rio Grande do Sul, de acordo com a Secretaria Estadual de Saúde (SES), se houver caso suspeito ou confirmado, existe um fluxo a ser seguido com medidas de contenção, envolvendo ações de prevenção e controle pelos serviços de saúde, conforme determinado pela nota técnica da Anvisa. O texto da SES explica que, ao identificar um paciente com o fungo, o serviço de saúde deve realizar seu isolamento imediato e "instituir as precauções que envolvem ações de prevenção e controle de infecções com ênfase na higiene das mãos, uso adequado de EPIs (equipamentos de proteção individual) e limpeza e desinfecção do ambiente e equipamentos", além de notificar a agência o mais rápido possível.
Infecções hospitalares
Alexandre Zavascki, chefe do Serviço de Infectologia do Hospital Moinhos de Vento, explica que o Candida auris é uma das espécies de fungo do gênero Candida, que causa infecções hospitalares. Outras espécies, como a Candida albicans, responsável pela doença popularmente conhecida como “sapinho”, geram o mesmo problema. A diferença, segundo o especialista, é que a Candida auris é muito resistente aos medicamentos antifúngicos disponíveis para o tratamento dessas infecções. Por isso, é chamada de “superfungo”.
— Essa espécie não causa doença em pessoas que têm imunidade normal ou que não estejam submetidas a determinadas intervenções que só acontecem em hospitais, como uso de cateteres venosos ou urinários. Não é superagressiva, mas fica limitada ao ambiente hospitalar, que é onde temos pacientes fragilizados, então ela se aproveita para invadir o organismo — afirma.
Dificuldade de controle
O “superfungo” é transmitido por contato e a forma mais comum de transmissão no ambiente hospitalar, aponta Zavascki, é pelas mãos dos profissionais de saúde ou pelo uso de materiais contaminados, caso não tenham sido higienizados adequadamente:
— Normalmente, dentro do hospital, o Candida auris infecta cateteres, que são colocados na veia do paciente e, a partir disso, o fungo atinge a corrente sanguínea, podendo se alojar em outros órgãos. Também pode causar infecção urinária em quem usa sonda e infecções em feridas operatórias, principalmente no abdômen.
De acordo com o especialista, uma pessoa pode pegar o Candida auris e não ter uma infecção — neste caso, ela está “colonizada” e pode servir como um vetor para levar o fungo a outro indivíduo. Assim, o fungo não é considerado agressivo e não representa um grande risco para a população saudável, que está fora do ambiente hospitalar. O problema, alerta Zavascki, é que acaba sendo difícil eliminá-lo por completo depois que ele entra nesses locais.
— O risco maior é dentro do ambiente hospitalar, para pessoas que já estão debilitadas. Para eliminar o fungo, precisa desse alerta máximo para pegá-lo em um momento inicial, porque pode acontecer de ser transmitido para vários pacientes. Então, precisa de medidas de bloqueio, identificar precocemente os infectados e colonizados. Exige uma ampla mobilização dos serviços de controle de infecção — destaca.
Diagnóstico e capacidade de adaptação
Outro fator de complicação apontado por Zavascki é a dificuldade de identificar o Candida auris pelos métodos mais tradicionais de microbiologia.
Carolina Mallmann Wallauer, biomédica especialista em Microbiologia Clínica e professora dos cursos de Biomedicina, Farmácia e Medicina da Ulbra, esclarece que, ao contrário da maioria dos fungos ambientais, ele apresenta tolerância a temperaturas elevadas, entre 37°C a 42°C, possui capacidade de sobreviver a condições ambientais adversas por longos períodos, como semanas ou meses, e consegue se adaptar fora do hospedeiro humano, o que aumenta consideravelmente o risco de surtos hospitalares.
— Além de ser resistente às principais drogas antifúngicas que hoje são utilizadas no tratamento de micoses, ele também é resistente a diversos desinfetantes que são utilizados em ambiente hospitalar — diz Carolina, reforçando que a prevenção inclui a colaboração de profissionais da saúde, familiares e pessoas próximas aos infectados, e medidas como a higienização correta das mãos, uso de aventais e luvas, e limpeza adequada dos ambientes.



